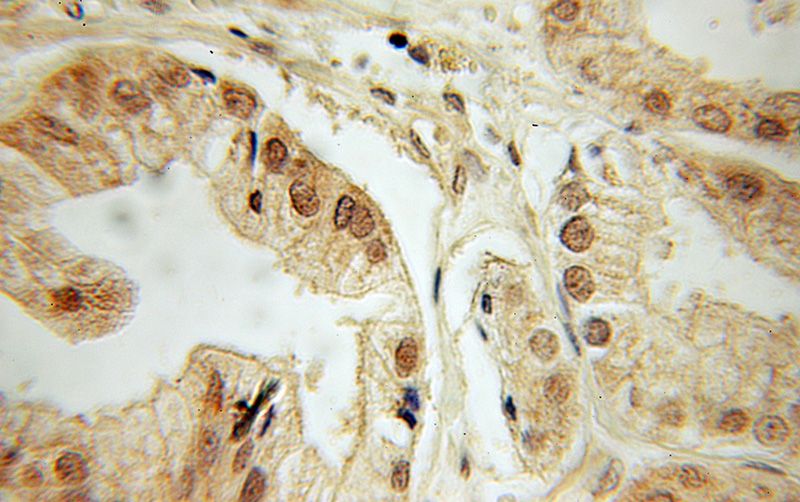
Immunohistochemical of paraffin-embedded human prostate cancer using Catalog No:109846(DEDD antibody) at dilution of 1:50 (under 10x lens)

-
Product Name
DEDD antibody
- Documents
-
Description
DEDD Rabbit Polyclonal antibody. Positive IHC detected in human prostate cancer tissue.
-
Tested applications
ELISA, IHC
-
Species reactivity
Human; other species not tested.
-
Alternative names
CASP8IP1 antibody; DEDD antibody; DEDD1 antibody; DEDPro1 antibody; DEFT antibody; FLDED 1 antibody; FLDED1 antibody; KE05 antibody
-
Isotype
Rabbit IgG
-
Preparation
This antibody was obtained by immunization of DEDD recombinant protein (Accession Number: NM_004216). Purification method: Antigen affinity purified.
-
Clonality
Polyclonal
-
Formulation
PBS with 0.1% sodium azide and 50% glycerol pH 7.3.
-
Storage instructions
Store at -20℃. DO NOT ALIQUOT
-
Applications
Recommended Dilution:
IHC: 1:20-1:200
-
Validations
Immunohistochemical of paraffin-embedded human prostate cancer using Catalog No:109846(DEDD antibody) at dilution of 1:50 (under 10x lens)
-
Background
DEDD, a member of a family of death effector domain-containing proteins, plays crucial roles in mediating apoptosis, regulating cell cycle, and inhibiting cell mitosis. DEDD may be a novel tumor repressor, which impedes metastasis by reversing the epithelial–mesenchymal transition (EMT) process in breast and colon cancers (PMID: 24839027).
-
References
- Lv Q, Hua F, Hu ZW. Use of the tumor repressor DEDD as a prognostic marker of cancer metastasis. Methods in molecular biology (Clifton, N.J.). 1165:197-222. 2014.
Related Products / Services
Please note: All products are "FOR RESEARCH USE ONLY AND ARE NOT INTENDED FOR DIAGNOSTIC OR THERAPEUTIC USE"
